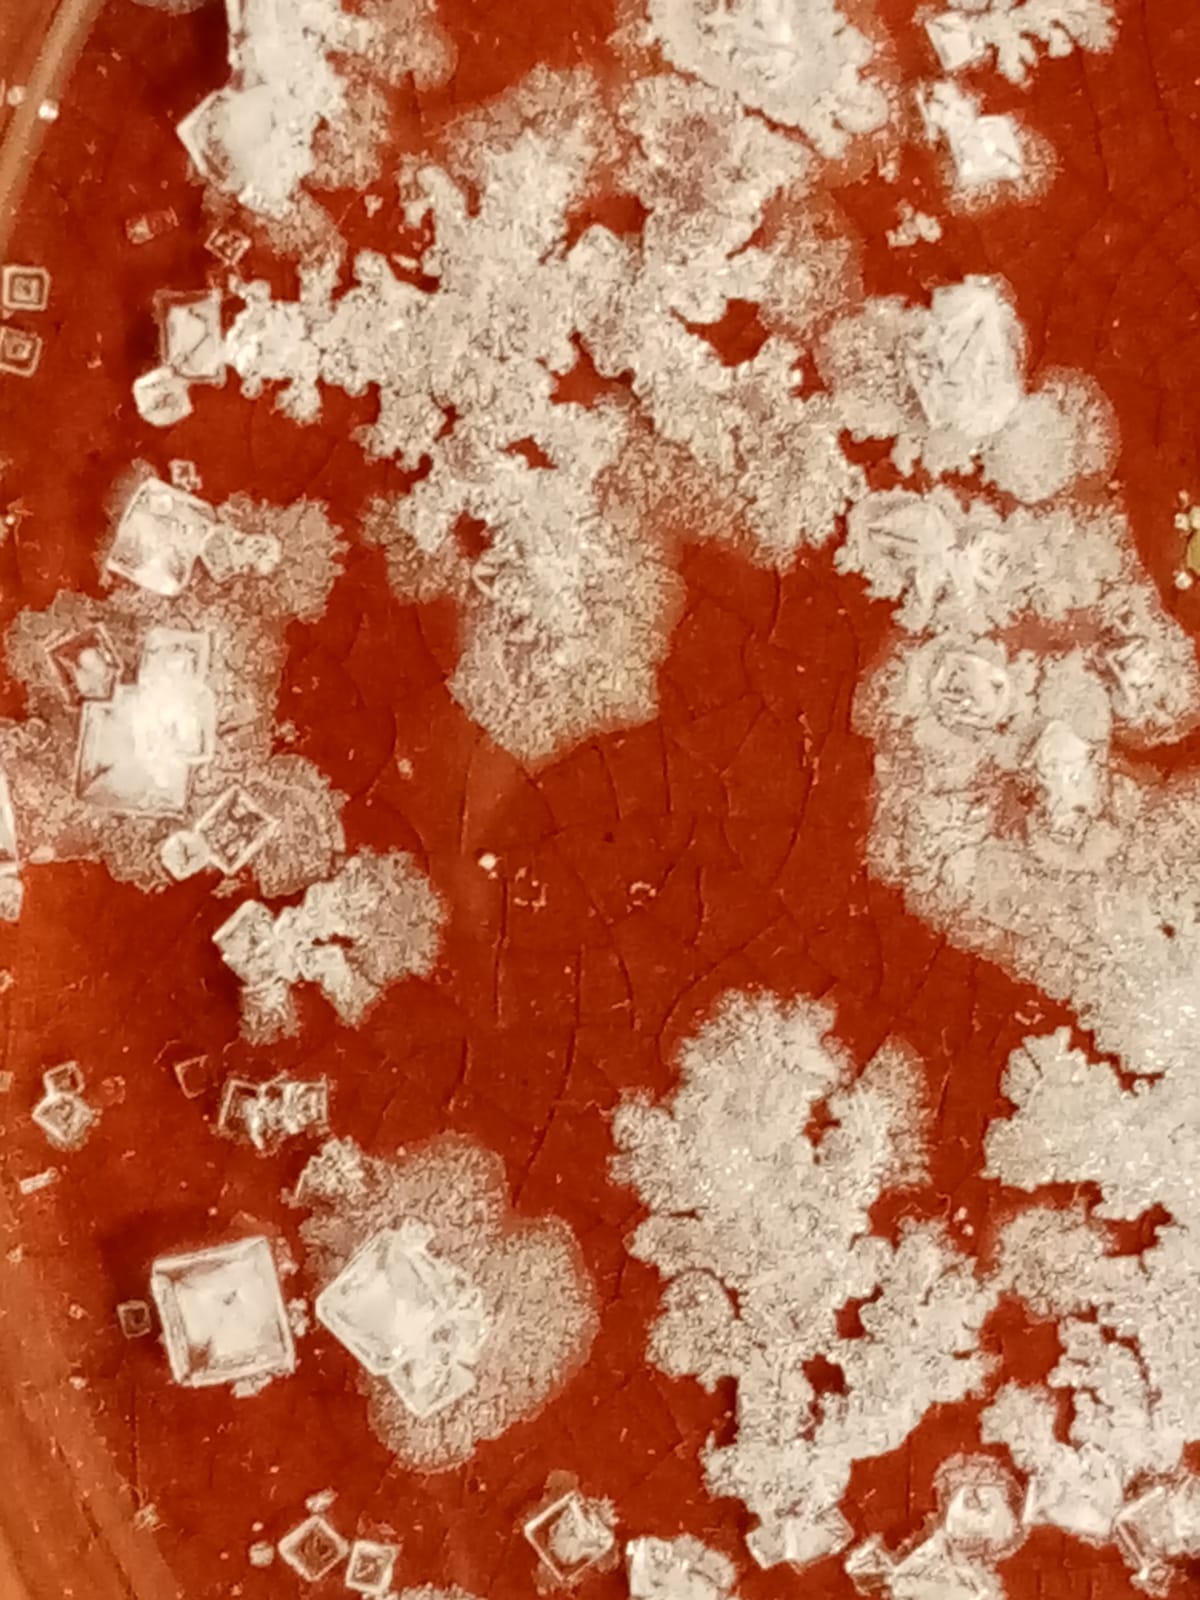
cristalls cristalls

Què estàs cercant?
Potser busques…
Lectures performàtiques del Manifest Anarcafeminista de Chiara Bottici
Públic general
Activitat oberta a tothom i gratuïta amb aforament limitat
La ManiFestA són un conjunt de lectures performàtiques del Manifest Anarcafeminista de Chiara Bottici, les quals a través de l’actuació del discurs filosòfic, obren la possibilitat de fer el cos subjecte del pensament. Què passa quan el cos en moviment impacta en els discursos feministes contemporanis? És el cos capaç de transformar-los? Pot el cos alliberar allò que el discurs captura?
Chiara Bottici, filòsofa feminista italiana i actualment professora de filosofia i directora dels Estudis de Gènere a The New School of Social Research, ha dedicat la darrera part de la seva producció teòrica –A Feminist Mythology (2021), Anarchafeminism (2021), Manifiesto Anarcafeminista (2021)– a l’elaboració d’una proposta anarcafeminista: una teoria i praxis que s’edifica sense arché i, per tant, que no vol explicar l’opressió de gènere través d’un únic principi. És en aquest sentit que, posant èmfasi en les contínues interseccions de classe, raça, sexualitat, hetero- i cis- normativitat, l’anarcafeminisme de Bottici dona compte del caràcter processual de la identitat i advoca per una filosofia de la transindividualitat que no exclou cap expressió identitària. Així, en la mesura que els cossos són plurals i plural és també la seva opressió, Bottici defensa que plurals també han de ser les estratègies per combatre aquesta opressió.
Enmmarcada en el context del Dia Internacional de les Dones, doncs, la La ManiFestA té lloc com una estratègia corporal, com un conjunt de lectures performàtiques que, posant el cos al centre de la praxis emancipatòria, exploren les possibilitats que el text esbossa per fer front a l’opressió del gènere. Contra la violència perpetuada en nom del binarisme de gènere, l’homofòbia i la transfòbia, nosaltres les anarcafeministes exigim l’alliberament de totes les dones. Not one less! Ni una menys! O totes som lliures, o cap de nosaltres ho serà.
A càrrec de Chiara Bottici i artistes residents del Santa Mònica
En col·laboració amb: Master Mundus Europhilosophie, Universitat Autònoma de Barcelona